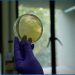
Centre for Cellular and Molecular Biology Innovates on AWS to Advance Genomics Research in India

Dr Revathi Srinivasan, Director of the Singhania Group of Schools, Mumbai has been recognized for her unwavering dedication and exceptional contributions to the field of education and given the title of ‘Global Icon and Inspirational Global Leader in Education’. She was awarded at the House of Lords located within British Parliament. Ms. Susan Kramer, a prominent member of the House of Lords, and Councillor Sunil Chopra, the Mayor of Southwark presented her the title at a special ceremony.
Beyond her administrative roles, Dr. Srinivasan is celebrated as an accomplished orator and a dedicated reader. She has graced prestigious international universities and forums with her enlightening keynote speeches. These engagements span a wide array of topics, ranging from pedagogical innovations and skill development to leadership, education redefinition, and global teaching-learning processes. Her captivating addresses have left an indelible mark on institutions such as the University of Aalborg in Denmark, the Education Council of Scotland, the Quality Council of India, and many others.